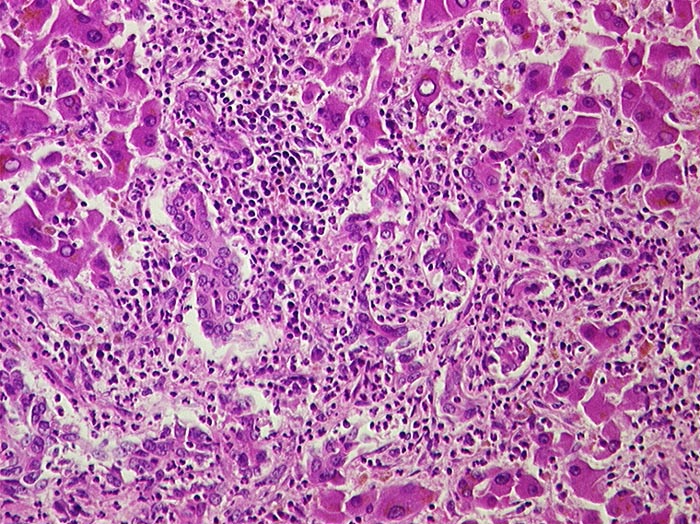

PathoPic – image database / PathoPic ID 888 - Eitrige Cholangitis
de
Diagnose
Eitrige Cholangitis
Diagnose Gruppe
Entzündung infektiös
Topographie
Leber
Topographie Gruppe
Leber, Gallenwege, Pankreas
Beschreibung
Portalfeld in der unteren Bildhälfte mit dichtem granulozytärem Entzündungsinfiltrat, welches auf die Gallengänge übergreift.
Zusatzbefund
Metastasierendes Pankreaskarzinom mit Tumorbefall von Ductus choledochus und cysticus.
Bilder Typ
Histologie
Alter
77
Geschlecht
männlich
Datum
Ersteintrag: 22.11.2001
Update: 04.02.2024